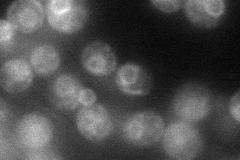
YCL025C
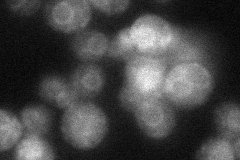
YCL025C

View description
Low-affinity amino acid permease with broad substrate range, involved in uptake of asparagine, glutamine, and other amino acids; expression is regulated by the SPS plasma membrane amino acid sensor system (Ssy1p-Ptr3p-Ssy5p)
Localization:
Intensity:
Fold change:
Significance:
-
C’ GFP library in SD

punctate32.18 -
N' NOP1pr-GFP in SD
ER60.3589 -
N' TEF2pr-mCherry in SD

cell periphery,vacuole66.6869 -
N' NATIVEpr-GFP in SD
ER45.3078 -
N' TEF2pr-VC and Cyto-VN in SD

below threshold27.5517 -
C’ GFP library in SD+DTT

punctate16.080.49Yes -
C’ GFP library in SD+H2O2

punctate21.770.67Yes -
C’ GFP library in Starvation Media

punctate22.790.7Yes -
C’ GFP library on the background of Pup2-DaMP

punctate -
C’ GFP library on the background of CCT mutant

punctate22.72460.706052No
